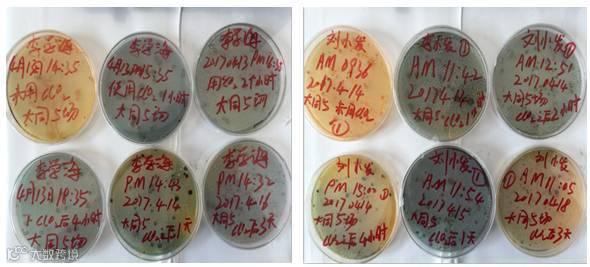
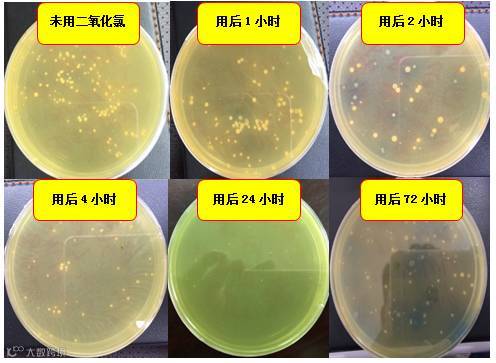
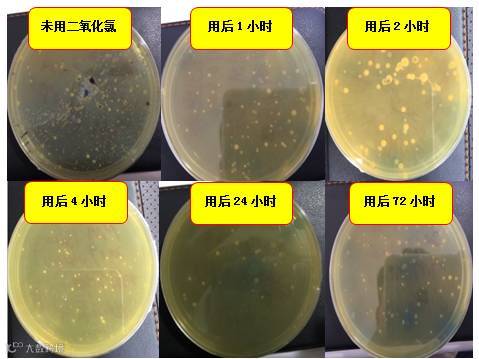

文 | 图 动保事业部 马召腾
一、背景介绍
湖北省洪湖市拥有20多万亩的草鱼养殖水面,然而每年的3-6月份就会大面积爆发草鱼疾病,导致常年草鱼养殖成活率难以超越70%的鸿沟。
海大研究院在4-6月份,对洪湖区域发病草鱼进行抽样调查,结果发现引起草鱼老三病(赤皮、肠炎、烂鳃)的病原主要是弧菌科气单胞菌属(如图1.1),而在弧菌科中对草鱼发病影响最大、危害最严重的就是嗜水气单胞菌。

图1.1 4-6月份洪湖区域草鱼致病菌种类
二氧化氯是一款安全高效的消毒剂。二氧化氯是溶于水呈现黄绿色的气体,在氧化过程中凭借cl4+到cl1-的5个电子转移,具有强氧化性。用有效氯表示,二氧化氯的氧化能力是氯气的2.63倍、高锰酸钾的2.4倍、双氧水(H2O2)的1.26倍(如图1.2)。因此二氧化氯凭借其超乎寻常的氧化能力,具备优势显著的杀菌效果。

图1.2 二氧化氯氧化能力对比
通过实验表明,对于水产养殖危害最大的嗜水气单胞菌,二氧化氯有效浓度只要达到0.15ppm,作用15分钟以后,有效杀灭率可以达到80%以上,并且随着二氧化氯使用浓度的增加和作用时间的延长,杀菌率也会逐渐提高。

图1.3 二氧化氯对嗜水气单胞菌的杀菌率
二、二氧化氯“杀菌现场”
为了进一步验证,海联科二氧化氯在养殖水体中,对嗜水气单胞菌的杀灭效率,我们在洪湖大同市场选择三口草鱼池塘,分别在海联科二氧化氯使用之前和使用后1小时、2小时、4小时、1天、3天取同一位置底层水,然后用一次性滴管取一滴水(0.029ml),均匀涂布在RS培养基上,倒置培养1-2天,然后观察嗜水气单胞菌生长状况。

图2.1 在李老板和刘老板使用海联科二氧化氯后取样观察
通过对二氧化氯使用前后,底层水样中嗜水气单胞菌数量变化监测,验证海联科二氧化氯的杀菌效率和作用时间,同时也根据池塘嗜水气单胞菌在被杀死之后的反弹规律,进一步指导我们在草鱼发病时如何正确的进行杀菌操作。
2.1 采样池塘基本信息
表2.1 采样池塘基本信息

三口池塘的面积和存塘量在洪湖草鱼养殖中极具代表性,也都是在最近10天内没有进行过杀菌操作,因此推测该池塘嗜水气单胞菌处于超标状态。
2.2 二氧化氯杀菌率跟踪
2017年4月13日下午开始跟踪李老板池塘,4月14日开始跟踪刘老板的两口池塘(如图2.2)。
图2.2 李老板和刘老板池塘RS培养基跟踪
把RS培养基倒置培养2天后,结果如图2.3和2.4所示:
图2.3 李老板池塘嗜水气单胞菌跟踪结果
图2.4 刘老板池塘嗜水气单胞菌跟踪结果
2.3 二氧化氯杀菌24小时后可补有益菌或再次杀菌

图2.5 三口池塘嗜水气单胞菌变化曲线
在未使用二氧化氯消毒时,池塘中嗜水气单胞菌均保持较高位的数值,无论是上午还是下午使用海联科二氧化氯,在使用之后的1-24个小时,池塘中有害菌都呈现明显下降趋势,并且在使用之后的2小时内,杀菌效率最高。2小时后有害菌下降变缓慢,但直到1天后仍在有效杀灭有害菌。所以二氧化氯使用之后,能在2小时内把池塘有害菌迅速降低到较低水平,并且在24小时内会持续保持杀菌力。
通过对杀菌后跟踪的几个时间节点看,海联科二氧化氯使用1天后杀菌率最高(如图2.6),三口池塘平均杀菌率可以达到88%。因此作为安全高效的消毒剂,二氧化氯在池塘中1天后可实现近90%的杀菌率。

图2.6 三口池塘海联科二氧化氯杀菌率
三口池塘海联科二氧化氯的用量分别是1包使用2.5、3、2亩水体,从杀菌率看,刘老板2池塘二氧化氯用量最大,那么4小时内杀菌速度也是最快,24小时后杀菌率最高(90.3%)。因此二氧化氯杀菌率随着使用剂量增大而增大,所以建议发病池塘可以把海联科二氧化氯适当提高剂量(2亩*米/包)以实现更高效消灭病原目的。
消毒后3天检测结果表明,池塘中嗜水气单胞菌开始有反弹迹象,有害菌浓度基本恢复到杀菌后1小时的水平,结合这几天天气状况(如图2.7),可以初步推测:二氧化氯杀菌1天后随着二氯浓度的消散有害菌会呈现再次慢慢反弹趋势;连续两天阴雨天气更适宜有害菌快速繁殖。
建议:
发病池塘在内服药物期间,可以连用两次二氧化氯消毒,这样可以为病鱼的恢复争取更长的少菌环境;
预防消毒池塘可以在使用二氧化氯1天后及时补充有益菌(3101),增加有益菌的生态占位;
同时在二氧化氯杀菌之后遇到连续阴雨天,建议天晴后再使用二氧化氯杀菌一次,遏制有害菌的反弹。

图2.7 洪湖区域天气变化情况
三、总结
虽然目前跟踪数据还有限,以后还需进一步验证,但从以上海联科二氧化氯“杀菌现场”的实况播报结果,仍然可以得出如下初步结论:
1、二氧化氯使用之后,能在2小时内把池塘有害菌迅速降低到较低水平,并且在24小时内持续保持杀菌力,24小时之后杀菌效率最高,可以达到近90%的杀灭率;
2、三口池塘都是在二氧化氯杀菌24小时之后杀菌效率最高,且之后会有反弹现象。因此建议:二氧化氯在常规预防性消毒24小时后,可以及时补充有益菌(3101),提升有益菌的生态占位,达到持续对有害菌的抑止作用;发病池塘在内服药物期间,可以连用两次二氧化氯消毒,这样可以为病鱼的恢复争取更长的少菌环境;
3、二氧化氯的杀菌率随着使用剂量增大而增大,所以建议发病池塘可以把海联科二氧化氯适当提高剂量(2亩*米/包),以实现更高效杀灭病原目的。
4、杀菌后遇到阴雨天,建议天晴再使用二氧化氯杀菌一次,遏制有害菌的反弹。
所以海联科二氧化氯对池塘中危害最大的嗜水气单胞菌杀灭效率明显,在华中池塘发病阶段可以很好的起到杀菌防病目的。但同时要学会根据天气和池塘鱼病情况灵活使用二氧化氯,这样才能实现更高效的消毒。




